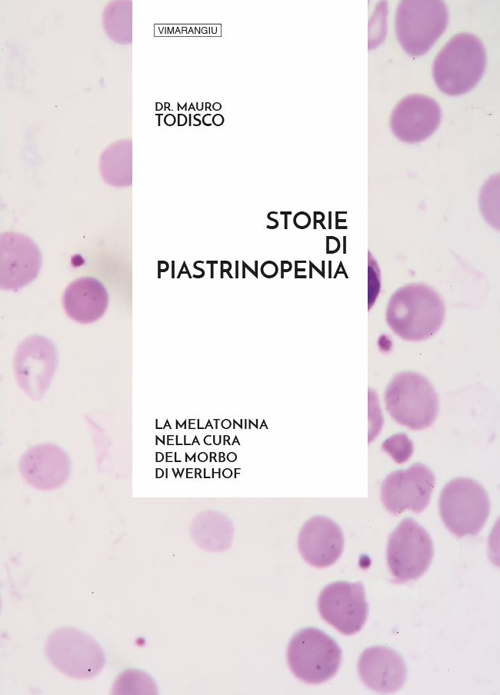
Storie di piastrinopenia. La melatonina nella cura del morbo di Werlhof

Autore
Mauro Todisco
9 libri disponibili per questo autore.

Verifica disponibilità
Storie di piastrinopenia. La melatonina nella cura del morbo di Werlhof
15,00 €

Verifica disponibilità
La resistibile essenza del cancro. Terapia di bella una cura da riconsiderare
18,00 €

Pagina 1 di 1
